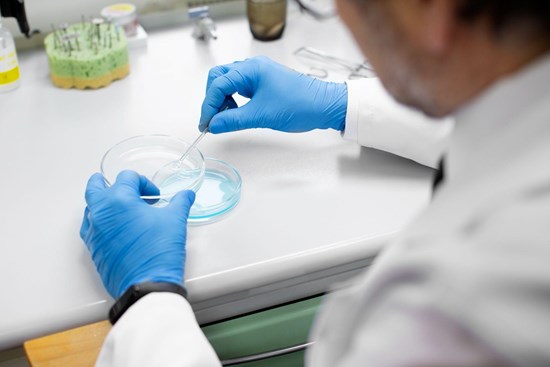
Cannot view this image? Visit: https://images.newsfilecorp.com/files/8871/285455_5e74899734072b35_002.jpg

Cambridge, Massachusetts--(Newsfile Corp. - March 10, 2026) - R3 Bio announced the release of its 2026 research report outlining early-stage progress in developing integrated, stem cell-derived biological platforms designed to reduce reliance on animal testing in preclinical research.

To view an enhanced version of this graphic, please visit:
https://images.newsfilecorp.com/files/8871/285455_5e74899734072b35_001full.jpg
The report details the company's focus on interconnected tissue systems that more closely replicate whole-organism biological dynamics, aiming to improve translational relevance in drug discovery and regenerative medicine. All research remains pre-commercial and exploratory.
Addressing Limitations in Preclinical Research
Image: Laboratory research in regenerative biology - Freepik
To view an enhanced version of this graphic, please visit:
https://images.newsfilecorp.com/files/8871/285455_5e74899734072b35_002full.jpg
R3 Bio focuses on biologically interconnected systems and integrated tissue networks rather than isolated organ models. Traditional preclinical research models often examine single tissues under controlled laboratory conditions. In contrast, the company studies cross-tissue biological architectures that reflect biological interactions seen in living organisms.
The company's approach reflects growing recognition that reductionist in vitro systems and animal research capture only part of human biology.
Single-model methodology can give a mechanistic understanding but can fail to capture feedback loops, metabolic interactions, and immune responses with effects on the outcome. Researchers are more in favor of strategies that assess interconnected systems of biological behavior.
Regulatory and Ethical Shifts in Research Standards
In this change, regulations are also shifting towards humane research alternatives that maintain the same rigor while promoting norms in ethical biomedical research. Overseeing agencies are considering approved alternatives to animal testing as part of a larger initiative to promote more human-relevant research.
The debate over regulatory matters across international borders encourages sponsors to obtain more data on outcomes across different models, underscoring the importance of cross-system assessment.
Ethical Alignment and Systems Integration
R3 Bio positions its exploratory programs within the broader shift toward ethically driven life sciences. The company focuses on responsible model development and ethics-forward scientific innovation as a part of its participation in morally responsible medical research.
The company also seeks to collaborate on therapeutic research with life-saving potential by creating multi-system regenerative platforms founded on lab-grown biological models as part of its efforts to provide alternatives to animal testing.
Within the broader regenerative medicine field, long-term scientific discussions include advanced tissue regeneration and other highly theoretical areas of investigation. These concepts remain complex and exploratory, including discussions around full-body replacement.
"The research economy is distorted by a gauntlet of complications that are directly downstream of animal testing, resolving those ethical issues resolves the primary impediments to progress," said Alice Gilman, chief operating officer of R3 Bio. "We are building platforms that reflect whole-body biological dynamics rather than studying isolated components which fail to reflect the most important full system interactions. Now the heaviest cost is no longer prohibitive. Unit price of insight will not be in lives."
R3 Bio continues to refine its approach to ethics-led regenerative science as part of its long-term contribution to life-preserving medical science and life-saving medical innovation, grounded in biomedical research and ethics-forward scientific innovation.
About R3 Bio
R3 Bio is a stealth-mode biotechnology company conducting exploratory research into systems-level biological platforms derived from stem cell research, reprogramming, and regenerative processes. The company focuses on developing integrated bio platform models designed to strengthen translational relevance and contribute to advancing life-saving therapies through responsible scientific design. The research is in its early stage, with no associated commercial product or clinical timeline.
Media Contact:
Name: Alice Gilman
Title: COO
Email: Alice@r3-bio.com
Phone: +15106605888
To view the source version of this press release, please visit https://www.newsfilecorp.com/release/285455
Source: PRNews OU